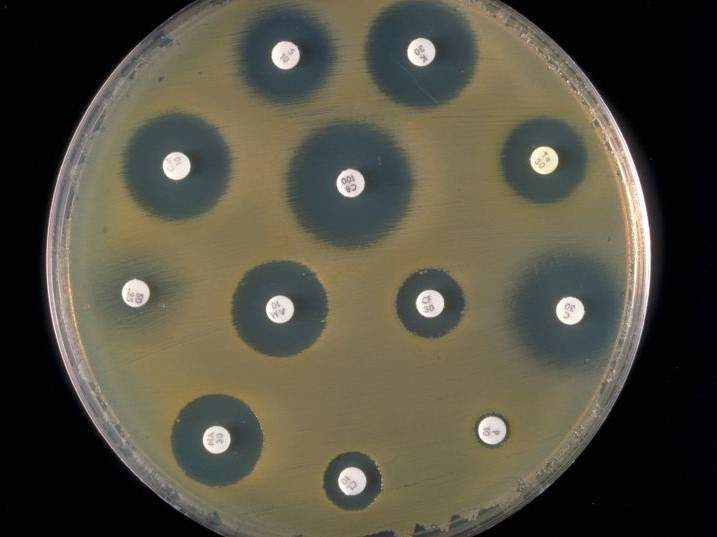
antimicrobial resistance

During the Agriculture and Fisheries Council, the Commission updated ministers on the state of play of the European Joint Action on Antimicrobial Resistance and Healthcare-Associated Infections (EU-JAMRAI) and outlined the next steps for this action.
Following this presentation, a number of ministers took the floor to express support for the Commission’s proposal to harmonise provisions on antimicrobial resistance across all member states.

The presidency concluded by emphasising the global aspect of the threat and the need to take action at international level.
JAMRAI state of play - information from the Commission
29 June 2021/ Consilium/ European Union.
https://www.consilium.europa.eu